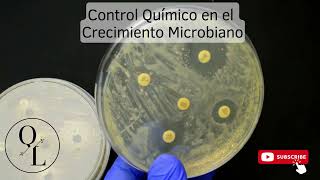

Químico Lapizco
Soy Químico Biólogo Clínico 👨🔬🥼⚗️💉 🩸 🧬 🦠 🧫 🧪 de Profesión y me encanta mi área de estudios, actualmente soy docente👨🏫 en una universidad privada.
Este canal será totalmente educativo, informativo y algunos tips en el área de la salud y de Laboratorio Clínico
Videos
Shared 2 years ago
418 views
Shared 2 years ago
482 views
Shared 2 years ago
227 views
Shared 2 years ago
438 views
Shared 2 years ago
120 views
Shared 2 years ago
2.3K views
Shared 3 years ago
290 views
Shared 3 years ago
251 views
Shared 3 years ago
367 views
Shared 3 years ago
1.6K views
Shared 3 years ago
3.5K views
Shared 3 years ago
12K views
Shared 3 years ago
92K views
Shared 3 years ago
5.5K views
Shared 3 years ago
4.8K views